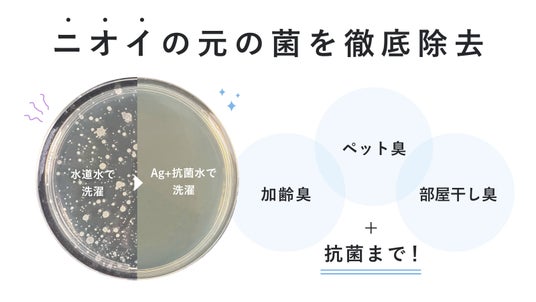

株式会社No.
Noend オーガニックファインバブル 洗濯機アダプターが2024年度グッドデザイン賞を受賞
株式会社No.(所在地:渋谷区)の洗濯機アダプターが2024年度グッドデザイン賞(主催:公益財団法人日本デザイン振興会)を受賞しました。この受賞を記念してプレゼントキャンペーンを10月16日(水)から実施しています。

■グッドデザイン賞受賞
“面倒な洗濯を、ぐんと楽に、効果的に、時短にしたい。”をテーマに、毛穴より小さいファインバブルが繊維の奥の汚れや洗濯槽まで洗浄し、活性炭フィルターで99%塩素除去!服の色落ちを防ぎ抗菌も可能な洗濯アダプター。ミニマルなデザインはインテリアになじみ、機能性のみならず人生の質を高め、洗濯のひとときをより豊かにする商品です。機能性の高さが伝わるシンプルなデザインが評価されました。
■審査員の評価
ファインバブルを発生させるには溶存酸素・水質や水圧などの条件を満たす必要があり、井戸水や夏場の水道水では、水中の溶存酸素が少なくバブルが発生しない。本製品は、給水栓と洗濯機の接続部でナノバブルを発生させる技術を開発した点が評価された。本体デザインとしてはシンプルながら、それぞれの役割が分かりやすく構成されており、活性炭フィルターが外観から見える点も新鮮である。
(出典元:グッドデザイン賞 公式サイト)
「グッドデザイン賞」受賞ページ:https://www.g-mark.org/gallery/winners/24105?years=2024

■プレゼントキャンペーン
今回の受賞を記念し、10月16日(水)からNoend公式インスタグラムアカウントにてプレゼントキャンペーンを実施します。
・公式アカウント: https://www.instagram.com/noend_beauty/

(1) 応募方法
NoendのInstagramアカウント( @noend_beauty )をフォロー&キャンペーン投稿にいいね
(2) 応募期間
2024年10月16日(水)~2024年11月15日(金)23:59
(3) プレゼント
・洗濯機アダプター1個
・フィルターケース1個(フィルター込み)
・フィルター1年分(5個)
※本体のカラー(ホワイト/グレー)は選べません。
※フィルターは2ヶ月で交換を推奨しております。
■製品について
Noendは洗濯のお悩みである「汚れを落としたい、でも色落ちはさせたくない」という矛盾に着目し、当社の“オーガニックファインバブル技術”と“活性炭フィルター”を併用することで、色落ちしにくく強い汚れを落とすことが可能なのではないかと考案。洗濯機で大量の泡を発生させて洗浄効果を得られる新技術「特殊エジェクター方式」を開発しました。毛穴よりも髪よりも微小なオーガニックファインバブルが繊維の奥の汚れまでキャッチ、さらに活性炭フィルターで色落ちや水垢の原因である塩素を99%除去します。
特殊エジェクター方式は今夏、特許を取得しました。



■オーガニックファインバブルの強力な洗浄力…当社「シャワーヘッド」での事例
Makuakeにて応援購入総額2,200万円超えを記録した「オーガニックファインバブルシャワーヘッド」の『オーガニックファインバブル』は、毛穴よりも髪よりも微小な1μm未満の泡です。目に見えないほどの微細な泡が、一般的な泡では落としにくい繊維の奥の汚れもキャッチ。毛穴の約1/300のサイズのオーガニックファインバブルが、今までの洗濯とは違う強力な洗浄力のポイントです。この強力な洗浄力で、洋服の汚れで気になる【襟の黄ばみ】や【シミ汚れ】も解決します。


■洗濯のたびに抗菌
さらに、活性炭フィルターにはAg+抗菌成分を添加。オーガニックファインバブルとともに繊維の奥に入り込み、衣類にしっかり浸透。洗濯のたびに抗菌して、部屋干し臭などのもとになる雑菌が衣類に繁殖するのを防ぎます。
■活性炭フィルターで99%塩素を除去
Noendの「オーガニックファインバブルシャワーヘッド」でも採用している活性炭フィルターを使用。この活性炭フィルターが、洗濯の色落ちの原因である塩素を99%除去します。洋服の色落ちは防ぎつつ、汚れをしっかり落とします。
さらに塩素除去で水質が軟化することにより水垢が減少、オーガニックファインバブルが洗濯槽の汚れも洗い流します。


《取り付け方法》
1.洗濯機のホースをはずす
2.給水口ネジに時計回りでアダプターを取り付け
3.アダプター上部にホースをもどす
どの洗濯機も取り付け方は同じく、「たて型」「ドラム式」どちらにも対応しています。

対応洗濯機:全自動洗濯機・たて型洗濯機・ドラム式洗濯機
対応していない洗濯機:二層式洗濯機
《製品仕様》

商品名:Noend オーガニックファインバブル
洗濯機アダプター
サイズ:H61.6mm/最大外径Φ30mm
重量:約130g
ネジ径:G3/4ねじ込み式
国内洗濯機共通 *二層式洗濯機を除く
最低水圧:0.1Mpa
耐熱温度:50℃

商品名:Noend オーガニックファインバブル
活性炭フィルターケース
サイズ:88mm × 37mm
重量:約54g

商品名:Noend オーガニックファインバブル
活性炭フィルター
サイズ:57mm × 23mm
重量:約6.3g
・Noendブランドコンセプトについて
「あなたにとって、いい暮らし」の中に、Noendが共にあることを目指して。
私たちNoendは、最高の完成形を目標とした、終わりのない技術の追求と改善をし続けます。
・No.(ノードット)について
所在地:東京都渋谷区恵比寿西1-30-10 代官山イルテンポ308
事業内容:ライフスタイルブランド「Noend」の商品企画、開発、販売、サポート
企業WEBサイト:https://noend.jp/
オフィシャルX:https://twitter.com/noend_official
オフィシャルInstagram:https://www.instagram.com/noend_beauty/
広報担当メールアドレス:press@nodot.co.jp




















